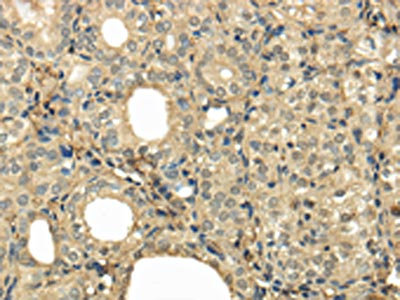

UBE2B Antibody
-
中文名稱:UBE2B兔多克隆抗體
-
貨號:CSB-PA170670
-
規格:¥1100
-
圖片:
-
其他:
產品詳情
-
Uniprot No.:
-
基因名:
-
別名:E2 17kDa antibody; E2 protein antibody; hHR6B antibody; HR6B antibody; RAD6 homolog B antibody; RAD6B antibody; UBC2 antibody; UBE2B antibody; UBE2B_HUMAN antibody; Ubiquitin carrier protein B antibody; Ubiquitin conjugating enzyme E2 B antibody; Ubiquitin conjugating enzyme E2B (RAD6 homolog) antibody; Ubiquitin conjugating enzyme E2B antibody; Ubiquitin protein ligase B antibody; Ubiquitin-conjugating enzyme E2 17 kDa antibody; Ubiquitin-conjugating enzyme E2 B antibody; Ubiquitin-conjugating enzyme E2-17 kDa antibody; Ubiquitin-protein ligase B antibody
-
宿主:Rabbit
-
反應種屬:Human,Mouse,Rat
-
免疫原:Full length fusion protein
-
免疫原種屬:Homo sapiens (Human)
-
標記方式:Non-conjugated
-
抗體亞型:IgG
-
純化方式:Antigen affinity purification
-
濃度:It differs from different batches. Please contact us to confirm it.
-
保存緩沖液:-20°C, pH7.4 PBS, 0.05% NaN3, 40% Glycerol
-
產品提供形式:Liquid
-
應用范圍:ELISA,IHC
-
推薦稀釋比:
Application Recommended Dilution ELISA 1:2000-1:5000 IHC 1:25-1:100 -
Protocols:
-
儲存條件:Upon receipt, store at -20°C or -80°C. Avoid repeated freeze.
-
貨期:Basically, we can dispatch the products out in 1-3 working days after receiving your orders. Delivery time maybe differs from different purchasing way or location, please kindly consult your local distributors for specific delivery time.
-
用途:For Research Use Only. Not for use in diagnostic or therapeutic procedures.
相關產品
靶點詳情
-
功能:Accepts ubiquitin from the E1 complex and catalyzes its covalent attachment to other proteins. In association with the E3 enzyme BRE1 (RNF20 and/or RNF40), it plays a role in transcription regulation by catalyzing the monoubiquitination of histone H2B at 'Lys-120' to form H2BK120ub1. H2BK120ub1 gives a specific tag for epigenetic transcriptional activation, elongation by RNA polymerase II, telomeric silencing, and is also a prerequisite for H3K4me and H3K79me formation. In vitro catalyzes 'Lys-11'-, as well as 'Lys-48'- and 'Lys-63'-linked polyubiquitination. Required for postreplication repair of UV-damaged DNA. Associates to the E3 ligase RAD18 to form the UBE2B-RAD18 ubiquitin ligase complex involved in mono-ubiquitination of DNA-associated PCNA on 'Lys-164'. May be involved in neurite outgrowth.
-
基因功能參考文獻:
- These data deepen insights into the vital role of RAD6/translesion synthesis in platinum drug tolerance and reveal clinical benefits of targeting RAD6 with SMI#9 for managing chemoresistant cancers. PMID: 28490629
- These results point to an important role of the affinity between RNF4 and its cognate RAD6B or UBCH5B in governing the multiplicity of substrate ubiquitination. PMID: 27678051
- In conclusion, we reveal that miR-455-5p expression is regulated by the TGF-beta-dependent pathway, which subsequently leads to UBE2B down-regulation and contributes to oral cancer tumourigenesis. PMID: 27235675
- These findings show the importance of Rad6 in ovarian cancer and emphasize the need for further studies of Rad6 as a potential target for the treatment of ovarian cancer. PMID: 26679603
- A novel variant (Chr5.133706925 A > G) residing in the UBE2B gene promoter region confers a high risk for idiopathic azoospermia in a Chinese population. PMID: 26223869
- UBE2B mRNA alterations are associated with severe oligozoospermia in infertile men. PMID: 23378580
- UBE2B polymorphisms g.-293T>G, g.20016A>G and g.9157A>G are not associated with male infertility, and the GA haplotype is likely a protective factor for male fertility in Northeast Chinese men. PMID: 23079972
- beta-catenin and Rad6B interacting regions, were identified. PMID: 22705350
- Hydroquinone could upregulate the expression of Rad6B in L-02 hepatic cells. PMID: 19548583
- The Rad6-Rad18 enzyme plays an essential role in promoting replication through DNA lesions by translesion synthesis in mammalian cells. PMID: 22547805
- Data show that the homodimeric Rad18 RING domain can recruit two Rad6b E2 enzymes, whereas the full-length Rad18 homodimer binds only to a single Rad6b molecule. PMID: 21549715
- Ubc2/Rad6 ser(120) regulates ubiquitin-dependent N-end rule targeting by E3{alpha}/Ubr1 PMID: 21041297
- Rad6B is a fundamental component of postreplication DNA repair and can be used as an independent marker for determining response to neoadjuvant chemotherapy. PMID: 19466589
- MCF10A cells stably transfected with antisense RAD6B display hypersensitivity to damage-inducing drugs. PMID: 14981545
- These data reveal a potentially important role for transcriptionally active beta-catenin in the regulation of Rad6B gene expression, and link aberrant beta-catenin signaling with transcriptional deregulation of Rad6B and breast cancer development. PMID: 17050667
- Findings reveal a positive regulatory feedback loop between Rad6B and beta-catenin and a novel mechanism of beta-catenin stabilization/activation in breast cancer cells. PMID: 18339854
- The SAP domain of RAD18 (residues 248-282) is crucial for binding of RAD18 complexed with RAD6B to DNA substrates. PMID: 18363965
- deletions in this suspected promoter region are associated with increased binding affinity for SP1, and might represent one of several factors required for alteration of UBE2B gene expression PMID: 18385908
- study suggests that the UBE2B gene is associated with male infertility in Indian men PMID: 18497339
顯示更多
收起更多
-
亞細胞定位:Cell membrane. Nucleus.
-
蛋白家族:Ubiquitin-conjugating enzyme family
-
數據庫鏈接:
Most popular with customers
-
-
YWHAB Recombinant Monoclonal Antibody
Applications: ELISA, WB, IHC, IF, FC
Species Reactivity: Human, Mouse, Rat
-
Phospho-YAP1 (S127) Recombinant Monoclonal Antibody
Applications: ELISA, WB, IHC
Species Reactivity: Human
-
-
-
-
-